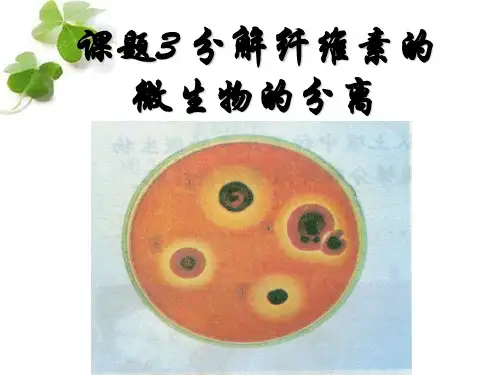

分解纤维素的微生物的分离知识点
- 格式:ppt
- 大小:214.00 KB
- 文档页数:14


分解纤维素的微生物的分离知识点纤维素是植物细胞壁的主要结构成分,通常与半纤维素、果胶和木质素结合在一起,其结合方式和程度对植物源食品的质地影响很大。
你知道纤维素的微生物怎么分离的吗?下面店铺给你分享分解纤维素的微生物的分离知识点,欢迎阅读。
分解纤维素的微生物的分离知识点一、纤维素与纤维素酶1.纤维素的化学组成含C、H、O三种元素,是一种多糖。
纤维素的基本组成单位是葡萄糖,人体内没有纤维素酶,所以人体不能直接以纤维素为能源物质,但土壤中有分解纤维素的微生物,最终把纤维素分解成葡萄糖释放到无机环境。
2.纤维素的分布棉花是自然界中纤维素含量最高的天然产物,此外,木材、作物秸秆等也富含纤维素。
纤维素产生于植物的光合作用,地球上的植物每年产生的纤维素超过70亿吨。
研究土壤中分解纤维素的微生物将给我们的生活带来很大变化。
3.纤维素酶的组分纤维素酶是一种复合酶,一般认为它至少包括C1酶、Cx酶和葡萄糖苷酶三种组分。
前两种酶使纤维素分解成纤维二糖,第三种酶将纤维二糖分解成葡萄糖。
二、纤维素分解菌的筛选1.方法刚果红染色法,常用的有两种,一种是先培养微生物,再加入刚果红进行颜色反应,另一种是在倒平板时就加入刚果红。
2.原理(1)含纤维素的培养基中加入的刚果红,可与纤维素形成红色复合物。
(2)当纤维素被纤维素酶分解后,形成的纤维二糖、葡萄糖不和刚果红发生这种反应,红色复合物就无法形成,培养基中出现以纤维素分解菌为中心的透明圈,可通过是否产生透明圈来筛选纤维素分解菌。
三、实验设计1.实验流程土壤取样→选择培养(此步可省略)→梯度稀释→将样品涂布到鉴别纤维素分解菌的培养基上→挑选产生透明圈的菌落。
2.土壤取样采取土样时,可以选择富含纤维素的环境。
3.选择培养(1)目的:增加纤维素分解菌的浓度,确保能够从样品中分离得到所需要的微生物。
(2)操作方法:将土样加入装有30 mL选择培养基的锥形瓶中,将锥形瓶固定在摇床上,在一定温度下振荡培养1~2_d,直至培养液变混浊,也可重复选择培养。


高二生物下册知识点:分解纤维素的微生物的分离生物学是自然科学的一个门类。
小编预备了高二生物下册知识点:分解纤维素的微生物的分离,期望你喜爱。
(1)实验原理:①土壤中存在着大量纤维素分解酶,包括真菌、细菌和放线菌等,它们能够产生纤维素酶。
纤维素酶是一种复合酶,能够把纤维素分解为纤维二糖,进一步分解为葡萄糖使微生物加以利用,故在用纤维素作为唯独碳源的培养基中,纤维素分解菌能够专门好地生长,其他微生物则不能生长。
②在培养基中加入刚果红,可与培养基中的纤维素形成红色复合物,当纤维素被分解后,红色复合物不能形成,培养基中会显现以纤维素分解菌为中心的透亮圈,从而可选择纤维素分解菌。
(2)实验过程:土壤取样:采集土样时,应选择富含纤维素的环境梯度稀释:用选择培养基培养,以增加纤维素分解菌的浓度梯度稀释涂布平板:将样品涂布于含刚果红的鉴别纤维素分解菌的固体培养基上选择产生中心透亮圈的菌落:产生纤维素酶的菌落周围显现透亮圈,考试技巧,从产生明显的透亮圈的菌落上挑取部分细菌,并接种到纤维素分解菌的选择培养基上,在30~37℃条件下培养,可获得较纯的菌种。
刚果红染色的两种方法的比较:先培养微生物,在加入刚果红在到平板时加入刚果红优点显示出的眼神反映差不多上是纤维素分解菌的作用操作简便,不存在菌落混杂问题缺点操作繁琐,加入刚果红溶液会使菌落之间发生混杂(1)由于琼脂和土豆汁中都含有淀粉类物质,能够使能够产生淀粉酶的微生物显现假阳性反应(2)有些微生物具有降解色素的能力,长时刻培养会降解刚果红,从而形成明显的透亮圈,这些微生物与纤维素分解菌不易区分知识拓展:1.纤维素与纤维素酶(1)纤维素①化学本质:一种多糖。
②分布:棉花是自然界中纤维素含量最高的天然产物,此外,木材、作物秸秆等也富含纤维素。
(2)纤维素酶①适应上,将纤维素酶分成三类:C1酶、Cx酶和葡糖苷酶。
C1酶是对纤维素最初起作用的酶,破坏纤维素链的结晶结构。
Cx酶是作用于经C 1酶活化的纤维素、分解-1,4-糖苷键的纤维素酶。


分解纤维素微生物的分离方法与技巧绪论近年来,随着环境污染问题的日益突出,分解纤维素的微生物研究变得越来越重要。
纤维素是一种复杂的多糖类化合物,其有效降解对于生物质资源的利用具有重要意义。
本文将介绍一些常用的分离方法与技巧,以期为相关研究提供参考。
一、物理分离方法1. 筛选法筛选法是常用的物理分离方法之一。
通过对样品进行适当的物理处理,如研磨、过筛等,可以将纤维素微生物与其他杂质分开。
这种方法简单易行,但存在一定的局限性,无法区分不同种类的微生物。
2. 显微镜观察法显微镜观察法可根据微生物的形态特征进行分离。
将纤维素样品放置在显微镜下进行观察,识别并分离出目标微生物。
这种方法适用于微生物数量较少的情况,但需要一定的显微观察技巧。
二、化学分离方法1. 酸碱处理法酸碱处理法通过调节样品的酸碱度来分离目标微生物。
纤维素微生物对酸碱度较敏感,可以利用这一特性实现分离。
例如,可以将样品浸泡在酸性溶液中,使纤维素微生物脱离样品并转移到溶液中,然后用适当的方法将其分离收集。
2. 加热处理法加热处理法是一种常用的化学分离方法。
纤维素微生物对高温较为敏感,通过加热样品可以使其脱离纤维素并转移到其他介质中。
例如,可以将样品加热至一定温度,使纤维素微生物被释放出来,然后采用适当的方法将其分离。
三、生物分离方法1. 生物筛选法生物筛选法是利用其他微生物对纤维素微生物的生物竞争关系来进行分离。
通过将待分离样品与其他微生物接种在同一培养基中,观察结果可以得出纤维素微生物的分离情况。
2. 培养方法培养方法是常用的生物分离方法。
可以利用纤维素微生物的特殊生长要求,构建适合其生长的培养基,从而分离目标微生物。
例如,可以选择添加纤维素作为碳源的培养基,利用纤维素微生物对碳源的特异性降解,进行分离。
结论分解纤维素微生物的分离方法与技巧多种多样,不同的方法适用于不同的研究目的和样品特点。
在实际应用中,需要根据具体情况选择合适的分离方法,并结合其他分析手段进行综合分析。




生物笔记分解纤维素的微生物的分离一、纤维素酶纤维素酶是一种复合酶,至少3种组分,即G酶,Cx酶和葡萄糖苷酶,在三种酶的共同作用下,纤维素最终被分解成葡萄糖。
二.纤维素分解的筛选在含有纤维素的培养基中加入刚果红时,刚果红与培养基中的纤维素形成红色复合物,当纤维素被纤维素酶分解后,刚果红——纤维素的复合物就无法形成,培养基中会出现以纤维素分解菌为中心的透明圈,可以通过是否产生透明圈来筛选纤维素分解菌。
湿地被誉为地球的“肾脏”受精的标志:在卵黄膜与透明带之间有2个极体的出现受精完成的标志:雌雄原核的融合DNA是遗传物质的载体。
染色体是基因的主要载体。
细胞膜的流动镶嵌模型由桑格和尼克森提出。
糖被(糖蛋白)作用:消化道和呼吸道上皮细胞表面的糖蛋白有保护和润滑作用,与细胞表面的识别有密切关系。
酶本质的探索法国巴斯德提出酿酒中的发酵是由于酵母细胞的存在。
德国李比希认为引起发酵的是酵母细胞中的某些物质,但这些物质只有在酵母细胞死亡并裂解后才能发挥作用。
德国毕希纳将酵母细胞中引起发酵的物质成为酿酶。
美国萨姆纳证明脲酶是蛋白质。
唾液pH为⒍2~⒎4 胃液的pH为0.9~1.5 小肠液pH为7.6动物体内的酶pH为6.5~8.0 植物pH为4.5~6.5植物组织培养的应用:1.快速繁殖花卉和蔬菜等作物。
2.拯救珍惜濒危物种。
3.结合基因工程培养作物新类型。
由碱基转录翻译成氨基酸,一般不考虑终止密码子。
克里克是第一个用实验证明遗传密码中3个碱基编码1个氨基酸的科学家。
基因突变在光学显微镜下是无法直接观察到的,而染色体变异却可以。
达尔文的自然选择学说揭示了生命现象的统一性是由于所有生物都有共同的祖先,生物的多样性是进化的结果。
河流:物理沉降、化学分解和微生物的分解。
人工建造“生态屏障”、“三北防护林”有效地防风阻沙。
恢复生态学主要利用的是生物群落演替理论。
植物激素:“激素杠杆”受精过程:精子穿越放射冠和透明带,进入卵黄膜,原核形成和配子结合。
分解纤维素的微生物的分离知识点分解纤维素的微生物是指能够分解植物纤维素的微生物,包括细菌、真菌和原生动物等。
纤维素分解微生物的分离是研究纤维素降解的关键步骤之一,需要一系列技术手段和实验方法。
以下是关于纤维素分解微生物的分离的一些知识点:1.分离介质的准备:为了分离纤维素分解微生物,需要准备一定的分离介质,常用的包括CMC(羟乙基纤维素钠)、氧化纤维素、纤维素硝酸酯等。
这些介质能够提供纤维素作为微生物的唯一碳源,并通过对媒介上的纤维素降解能力的检测来筛选分解能力强的微生物。
2.样品的收集与预处理:从自然环境中收集样品,如土壤、水体、动物肠道等,作为分离纤维素分解微生物的样品。
对于不同的样品,需要进行不同的预处理步骤,如土壤样品可能需要先进行筛分、稀释等,以获取适合的微生物样品。
3.纤维素分解菌的分离方法:常用的方法有网状过滤法、稀释平板法、涂布法和固体培养法等。
其中网状过滤法是将含有微生物的溶液经过一系列的精细滤网,用含纤维素降解酶活性的培养基滴洒在滤膜上,等待菌落的出现。
稀释平板法是将经过适当稀释后的微生物样品均匀涂布在含有纤维素的固体培养基上,将纤维素分解菌形成的菌落分离开,纯化得到纯种纤维素分解菌株。
涂布法则是将含有微生物的溶液均匀涂布于含有纤维素的涂料上,使纤维素降解菌后来形成的菌落附着在涂料上,然后将涂料悬浮于培养基中,得到分离的纤维素降解菌株。
4.分离纯化:通过以上方法获得菌落后,需要经过反复的分离纯化步骤,包括连续经过固体培养基的孢子形成、接种至液体培养基、分几次进行稀释平板和观察等步骤,以得到单个纯菌株。
5.鉴定和筛选:通过形态学、生理学和生化学方法对分离得到的纤维素分解微生物进行鉴定和分类。
同时,通过测定其纤维素降解酶活性和产生的代谢产物,评估其纤维素分解能力和代谢途径。
此外,还可以使用分子生物学方法,如16SrRNA测序和PCR等,对分离得到的微生物进行进一步的鉴定和分类。
6.构建工程菌株:通过基因工程技术,可以将纤维素降解酶基因导入到高效率发酵菌中,构建高纤维素降解能力的工程菌株,用于工业生产等。
第7课时 分解纤维素的微生物的分离学习目标 1.掌握纤维素酶的种类和作用及纤维素分解菌的筛选方法。
2.理解并掌握纤维素分解菌的筛选过程及刚果红染色法的原理。
3.掌握纤维素酶的测定方法。
一、纤维素分解菌的筛选1.纤维素与纤维素酶 (1)纤维素①基本组成单位:-----------。
②分布:主要分布在植物--------------等器官中。
特别提醒 纤维素的分布、主要性质和作用分布 棉花是自然界中纤维素含量最高的天然产物,此外,木材、作物秸秆等也富含纤维素主要性质 常温下比较稳定,不溶于水及一般有机溶剂;纤维素不具有还原性,但在一定条件下能进行水解反应,产生葡萄糖,故其水解产物具有还原性 作用植物细胞细胞壁的主要成分;一种重要的膳食纤维,具有刺激胃肠蠕动、促进消化液分泌的功能;此外纤维素可用于造纸、纺织、制造炸药等(2)纤维素酶①组成:是一种复合酶,至少包括三种组分,即C 1酶、C X 酶、葡萄糖苷酶。
②作用:纤维素―――――――→C 1酶和C X 酶纤维二糖―――――――→葡萄糖苷酶葡萄糖特别提醒 除自然环境中存在的分解纤维素的微生物外,在草食性动物牛、马、羊等的消化道内,也共生有分解纤维素的微生物,其可产生纤维素酶分解纤维素,而人体没有分解纤维素的能力。
2.纤维素分解菌的筛选 (1)方法:--------------。
①方法一:先培养------------,再加入-------------进行颜色反应。
②方法二:在------------时就加入刚果红。
特别提醒 方法一需要用NaCl 溶液洗去培养基表面浮色后,再进行观察,方法二不需要。
(2)原理纤维素+刚果红→红色复合物↓纤维素酶纤维二糖和葡萄糖,不能和刚果红形成红色复合物 ↓以--------------心的透明圈1.如何设计实验证明纤维素酶能分解纤维素?提示 设计对照实验。
取两支试管,分别加入等量的滤纸条和缓冲液,在一支试管中加入纤维素酶,另一支试管中加入等量蒸馏水,振荡反应一段时间后,可观察到加入纤维素酶的试管中滤纸条被水解,而加入蒸馏水的试管中滤纸条没有变化。